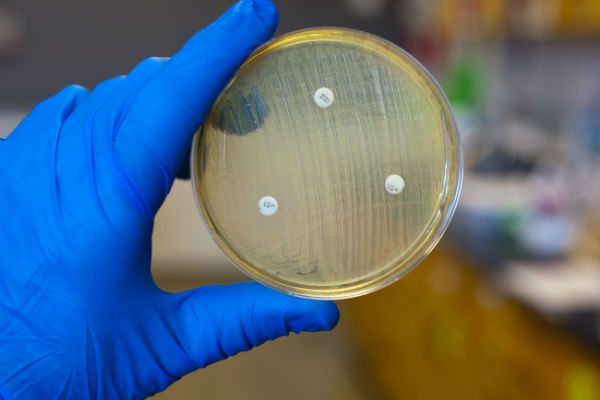

تعد آلام الرأس على الصدغين ومشاكل النظر من المتاعب الشائعة، التي يشتكي منها الجميع ذات مرة في حياته. ولكن إذا هاجمت هذه المتاعب الجسم للمرة الأولى بعد سن الخمسين، فإنها قد تكون أعراضاً لما يُعرف بـ "التهاب الشريان ذي الخلايا العملاقة"، الذي يستلزم العلاج الفوري رغم صعوبة تشخيصه لتجنب العواقب الوخيمة، التي قد تترتب عليه، مثل العمى.
ذكرت مجلة "دير شبيجل" الألمانية أن تكاليف علاج مريض إيبولا في مستشفى هامبورج إيبندورف الألماني الجامعي يمكن أن تصل إلى نحو مليوني يورو.
أظهر استطلاع ألماني حديث أن أغلب النساء في ألمانيا يشعرن بالاضطهاد في أماكن عملهن.
أعرب أخصائي الأمراض المعدية الألماني برنهارد روف عن رأيه في أن هناك نقص في الإجراءات الوقائية المتبعة أثناء علاج مرضى إيبولا في إسبانيا والولايات المتحدة الأمريكية.
قامت وزارة الخارجية الألمانية بتعديل تحذيراتها بشأن الرحلات النيلية بين مدينتي الأقصر وأسوان / أبو سمبل، حيث باتت لا تمانع من القيام بها وبرحلات إلي المناطق والمواقع الأثرية في جنوب وادي النيل.
تتيح شراكة رقمية جديدة بين شركة جوجل الامريكية العملاقة والمتحف الالمانى فى مدينة ميونيخ الالمانية لهؤلاء المهتمين بمقتنيات المتاحف مشاهدة هذه المقنيات عبر الإنترنت دون الحاجة إلى قطع المسافات الطويلة لزيارة المدينة الواقعة في جنوب ألمانيا.
تمثل الحواجب العريضة والكثيفة على غرار عارضة الأزياء العالمية كارا ديليفين أحدث صيحات الموضة هذا الموسم، بعدما تربعت على عرش الجمال في السنوات الماضية. وتمتاز الحواجب العريضة بأنها تمنح المرأة إطلالة طبيعية من ناحية، وترسم إطاراً للوجه من ناحية أخرى.
ذكرت مجلة "إن ستايل" الألمانية أن البنطال القماشي ذا الوسط العالي أو ذا الطيّات يتربع على عرش الموضة النسائية في خريف/شتاء 2014/2015، مشيرة إلى أن هذه الموضة مستوحاة من النجمات العالميات، مثل الممثلتين الأمريكيتين جيسيكا ألبا وجايمي كينغ وعارضة الأزياء روزي هنتنغتون وايتلي.
قال المركز الألماني لعلاج الأمراض العصبية إن ممارسة الرياضة تعمل على تنشيط الدورة الدموية الدماغية لدى كبار السن، كما أنها تسهم في تحسين أداء الذاكرة لديهم، استناداً إلى نتائج دراسة حديثة.
ذكرت مجلة "الآباء" الألمانية أن المرأة تحتاج خلال فترتي الحمل والولادة إلى حمّالات صدر خاصة، موضحة أنه خلال الشهور الأولى من الحمل ينبغي أن ترتدي المرأة حمّالة صدر رياضية مريحة.